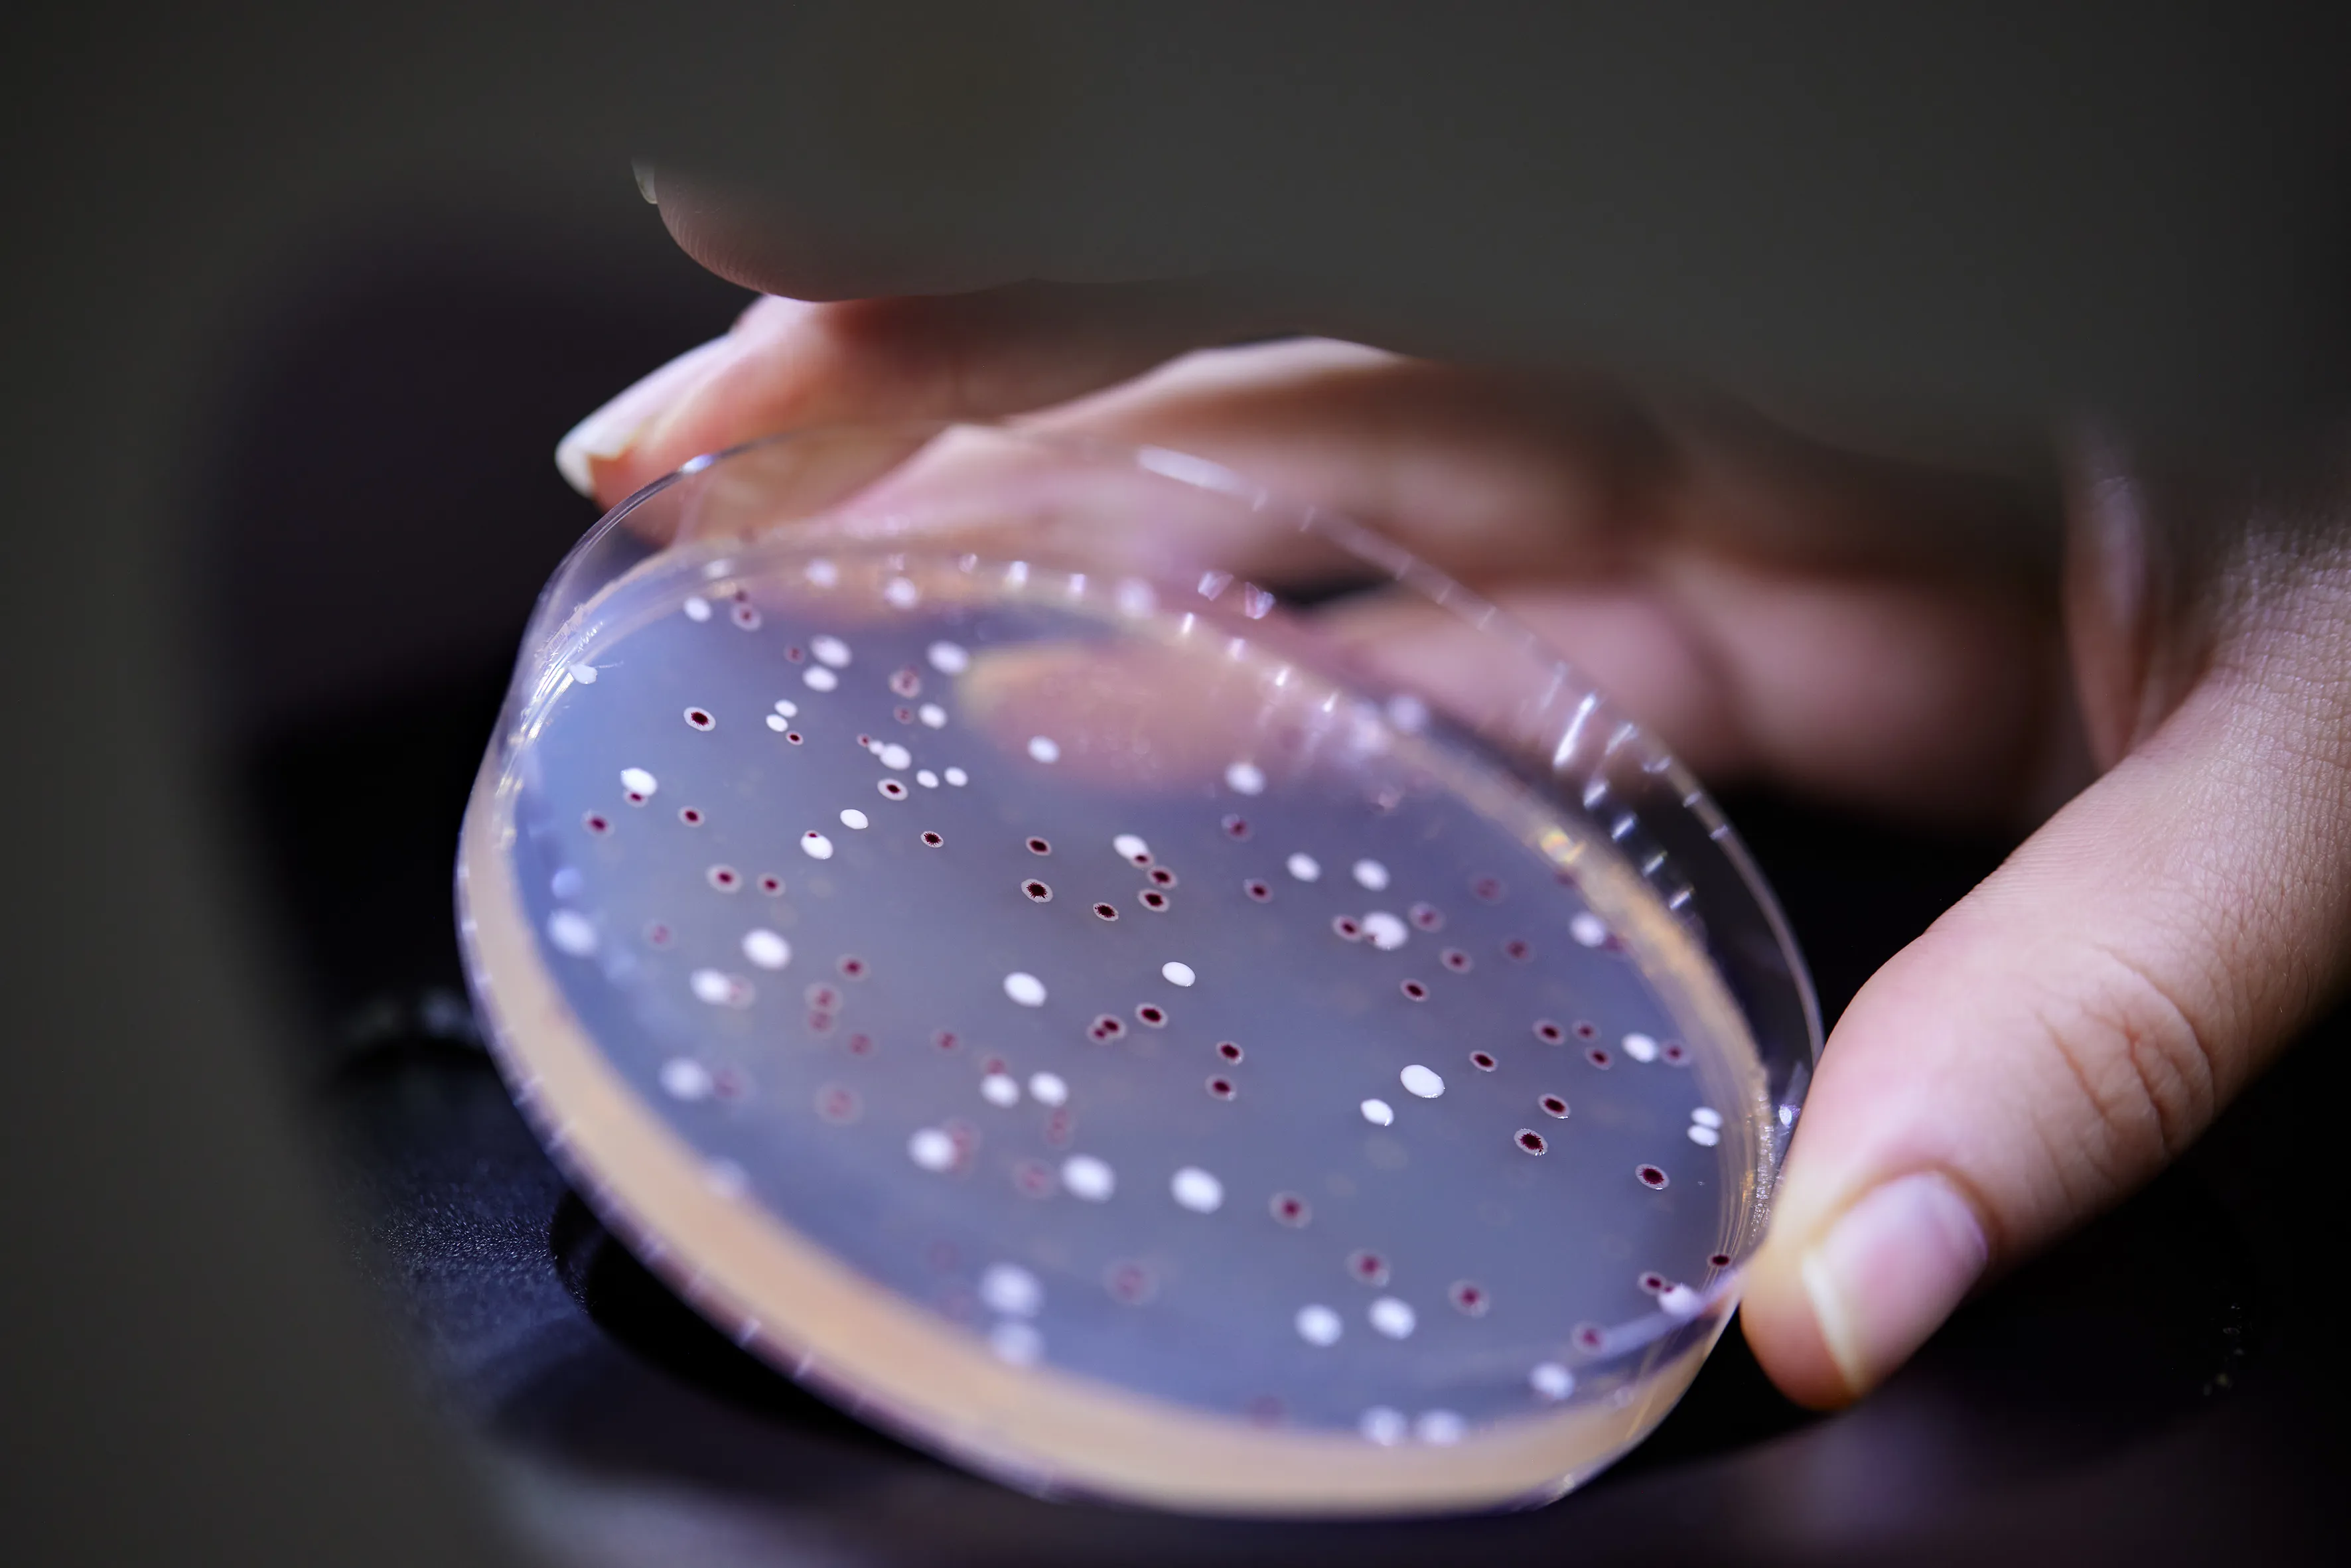
Lab8
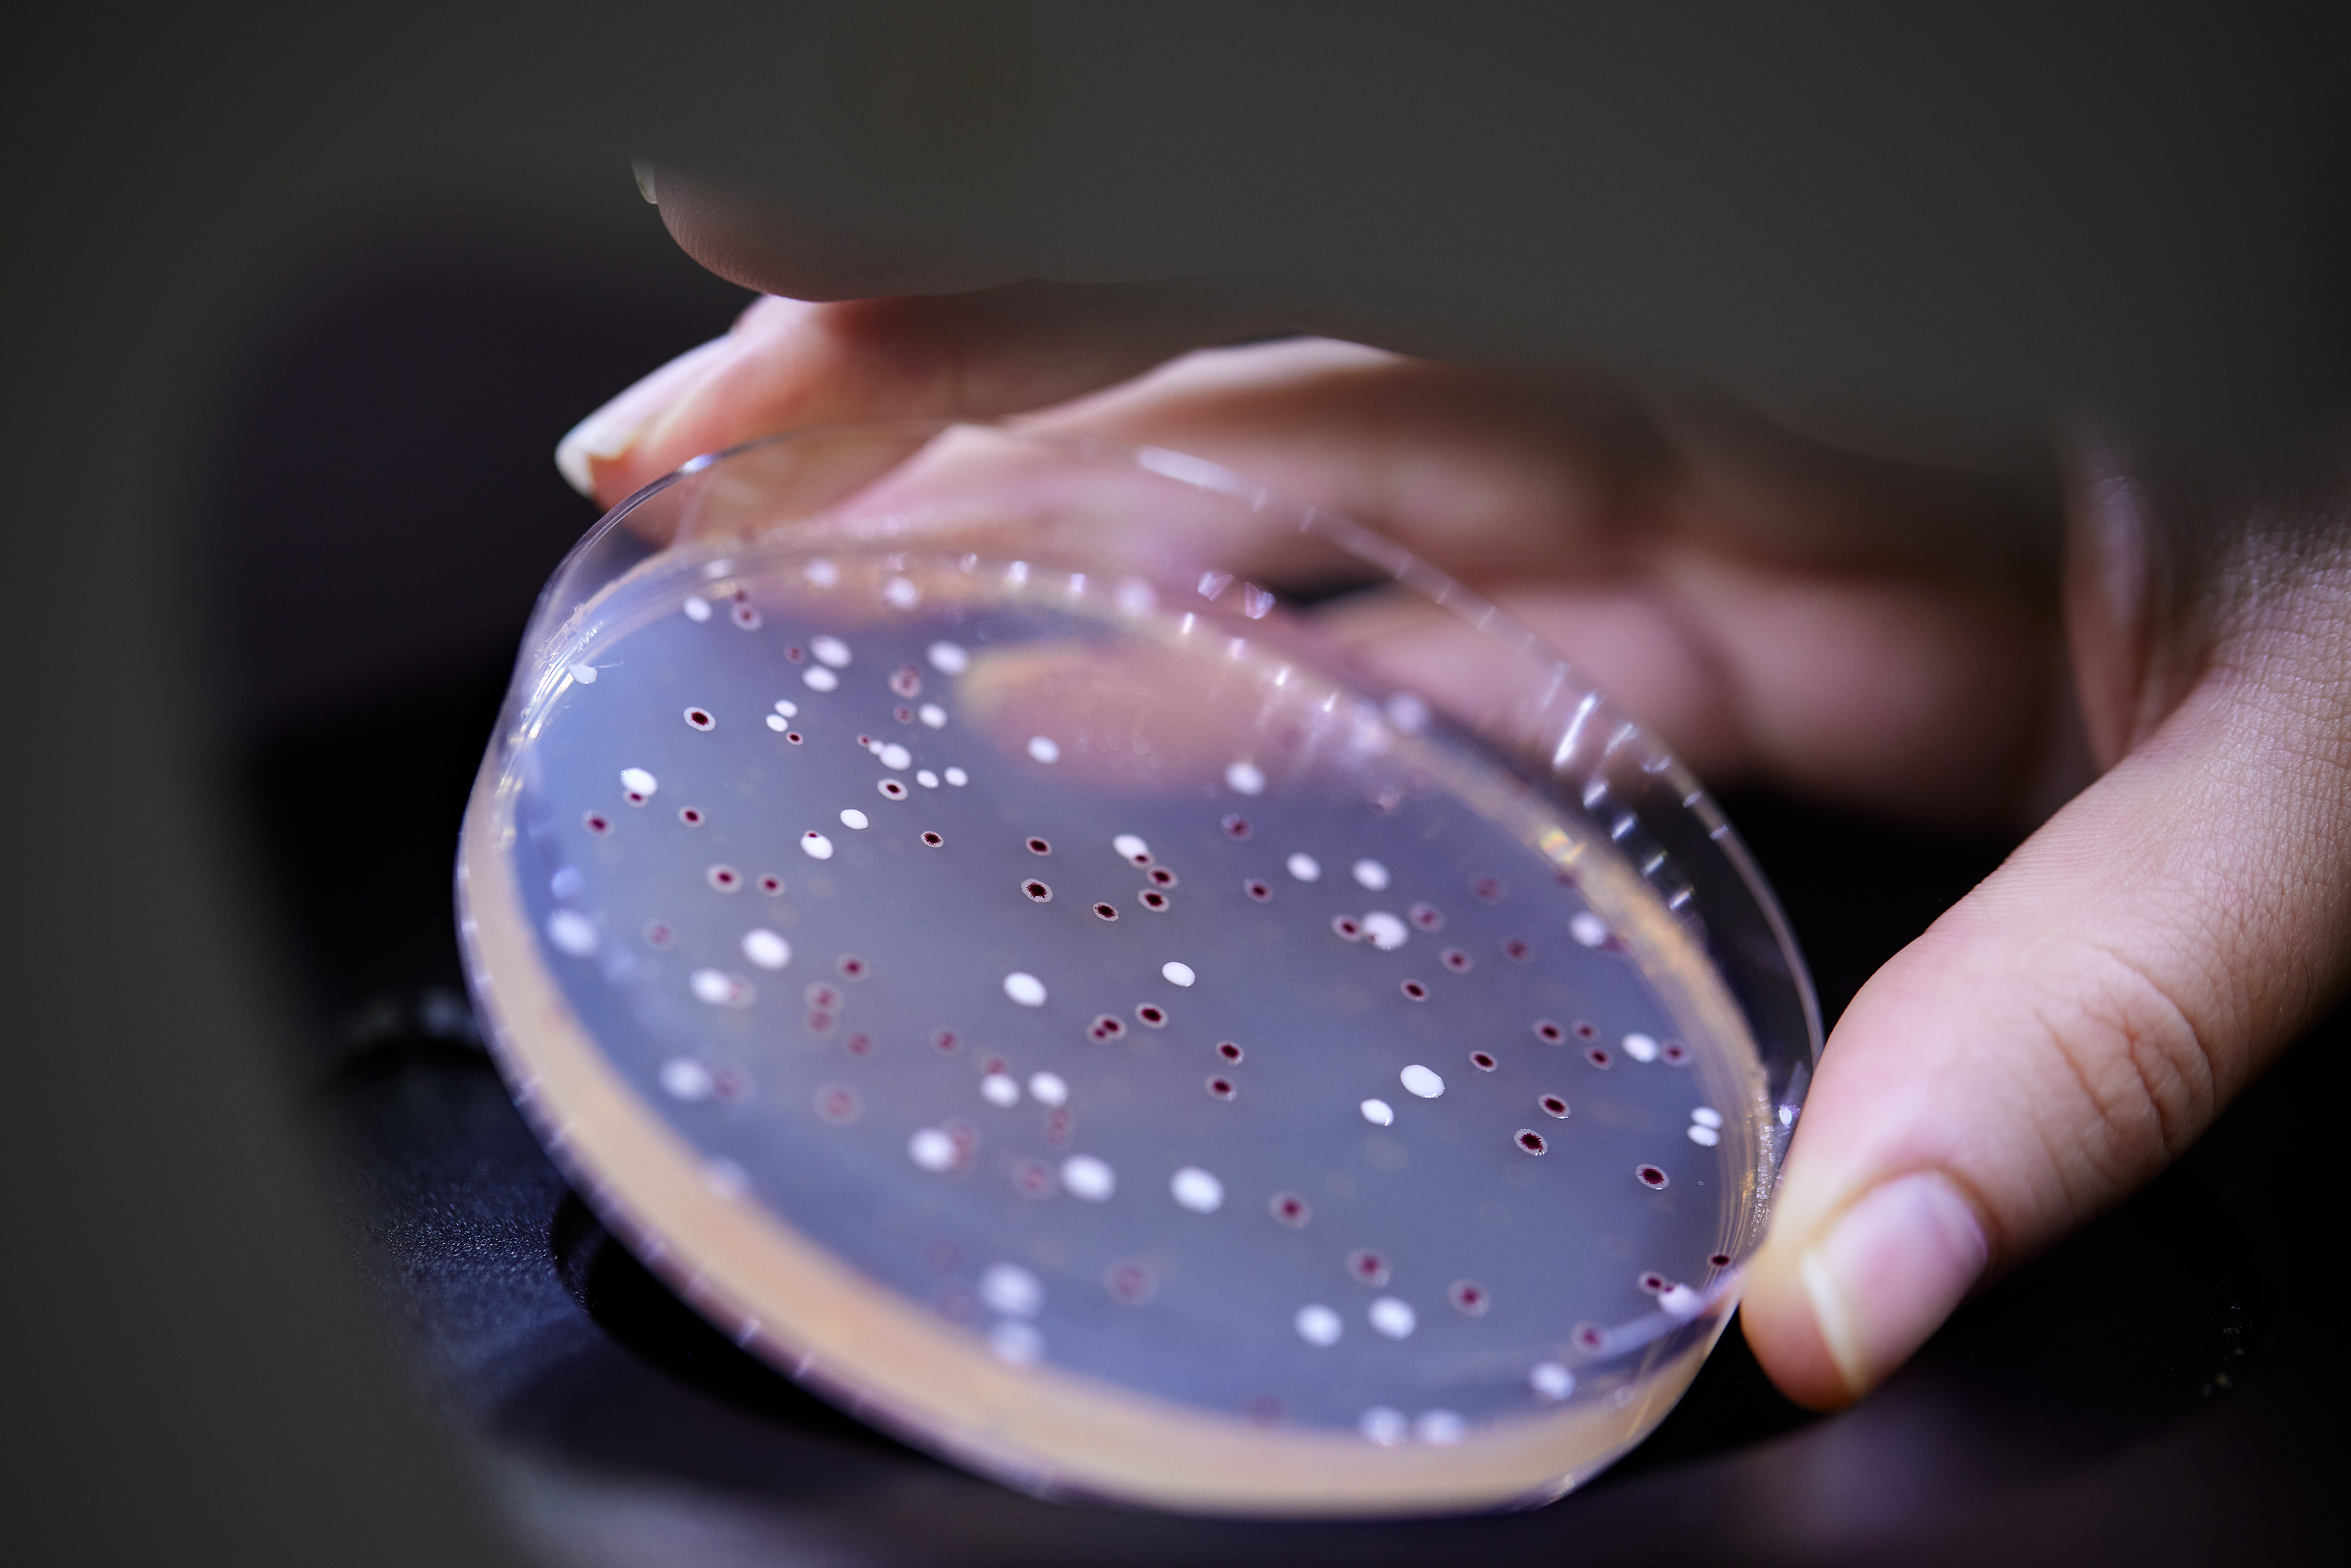
Lab8

Take the chance to meet our experts and explore the latest solutions for wellness and active living in New Jersey April 14–15!
We’re delighted to attending in-cosmetic in Paris, April 14–16, together with Symrise at stand 3E10. Don't miss Christina Vegge, R&D Director at Probi, participating at a panel discussion on April 15.
Probi is a global company focused exclusively on developing, producing, and delivering clinically proven biotic solutions.
For over three decades, we’ve specialized in developing, producing, and delivering clinically proven biotic solutions. Our expertise spans from R&D to manufacturing, ensuring stable, live bacteria in bulk formats, supplements, and functional foods, all supported by comprehensive documentation.
Founded in 1991 at Lund University in Sweden, Probi now operates in over 40 markets and holds more than 350 global patents. Probi is part of Symrise AG, further strengthening capabilities and global reach. As such, Probi leverages this combined strength to advance future-ready solutions in health and well-being.
In everything we do, Probi strives to be Credible, Curious, Committed and Clear. These values define who we are and guide our daily work and interactions with our colleagues, partners and customers.
Living our values means that we offer:

Probi® was born out of a visionary research project at Lund University, Sweden, whose aim was to discover whether administering...

Our people are our heart. Their contributions, knowledge, and devotion keep it beating. Probi® employees are innovative,...

Probi combines innovative R&D, a keen knowledge of the latest trends, and state-of-the-art research to develop proven...